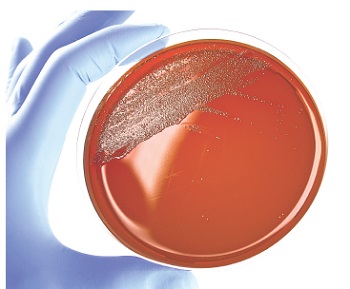

Cargando, por favor espere ...

Placas preparadas d=90 mm c/ medios de cultivo, LIOFILCHEM®
Material para ensayos y análisis microbiológicos
| C¾digo | Descripci¾n | Disponibilidad | Cantidad |
|---|---|---|---|
| 2135101034 | Aeromonas Agar, 20 plates 90 mm, Selective Medium for Aeromonas spp. Isolation, 20 cajas, LIOFILCHEM« | 5/12 dĒas | 1 |
| 2135101035 | Anaerobic Agar, 20 plates 90 mm, 20 cajas, LIOFILCHEM« | 5/12 dĒas | 1 |
| 2135101036 | Antibiotic Agar No. 1, 20 plates 90 mm, 40 cajas, LIOFILCHEM« | 5/12 dĒas | 1 |
| 2135101040 | Azide Agar (Sheep blood 5%), 20 plates 90 mm, Selective medium for streptococci isolation, LIOFILCHEM« | 5/12 dĒas | 1 |
| 2135101041 | Azide Agar (Sheep blood 5%), 100 plates 90 mm, Selective medium for streptococci isolation, LIOFILCHEM« | 5/12 dĒas | 1 |
| 2135101048 | Bacillus cereus Agar (MOSSEL, MYP), 20 plates 90 mm, Selective medium for Bacillus cereus isolation and enumeration, LIOFILCHEM« | 5/12 dĒas | 1 |
| 2135101049 | Bacillus cereus Agar (PEMBA), 20 plates 90 mm, Selective medium for Bacillus cereus isolation and enumeration, 10 cajas, LIOFILCHEM« | 5/12 dĒas | 1 |
| 2135101051 | Baird Parker Agar (Egg yolk tellurite), 20 plates 90 mm, Selective medium for Staphylococcus aureus isolation in food, LIOFILCHEM« | 5/12 dĒas | 1 |
| 2135101052 | Baird Parker Agar (Egg yolk tellurite), 100 plates 90 mm, Selective medium for Staphylococcus aureus isolation in food, LIOFILCHEM« | 5/12 dĒas | 1 |
| 2135101053 | Baird Parker Agar + RPF, 20 plates 90 mm, Selective medium for Staphylococcus aureus isolation, LIOFILCHEM« | 5/12 dĒas | 1 |
| 2135101055 | Biggy (Nickerson) Agar, 20 plates 90 mm, Selective medium for Candida spp. isolation and presumptive identification, LIOFILCHEM« | 5/12 dĒas | 1 |
| 2135101056 | Biggy (Nickerson) Agar, 100 plates 90 mm, Selective medium for Candida spp. isolation and presumptive identification, LIOFILCHEM« | 5/12 dĒas | 1 |
| 2135101059 | Bile Aesculin Agar, 20 plates 90 mm, Selective medium for group D streptococci isolation, LIOFILCHEM« | 5/12 dĒas | 1 |
| 2135101060 | Bile Aesculin Agar, 100 plates, Selective medium for group D streptococci isolation, LIOFILCHEM« | 5/12 dĒas | 1 |
| 2135101064 | Bile Aesculin Azide Agar w/ Vancomycin, 20 plates 90 mm, Selective medium for isolating Vancomycin-resistant enterococci, 10 cajas, LIOFILCHEM« | 5/12 dĒas | 1 |
| 2135101066 | Biotone Agar, 20 plates 90 mm, 30 cajas, LIOFILCHEM« | 5/12 dĒas | 1 |
| 2135101067 | Bismuth Sulfite Agar, 20 plates 90 mm, Selective medium for Salmonella spp. Isolation, LIOFILCHEM« | 5/12 dĒas | 1 |
| 2135101068 | Bismuth Sulfite Agar, 100 plates 90 mm, Selective medium for Salmonella spp. Isolation, LIOFILCHEM« | 5/12 dĒas | 1 |
| 2135101069 | Bismuth Sulphite Agar ISO 6579-1 2017, 20 plates 90 mm, Selective medium for Salmonella spp. Isolation, LIOFILCHEM« | 5/12 dĒas | 1 |
| 2135101070 | Blood Agar Base (Sheep blood 7%), 20 plates 90 mm, Medium for fastidious microorganisms isolation and for haemolysis test, LIOFILCHEM« | 5/12 dĒas | 1 |
| 2135101071 | Blood Agar Base (Sheep blood 7%), 100 plates 90 mm, Medium for fastidious microorganisms isolation and for haemolysis test, LIOFILCHEM« | 5/12 dĒas | 1 |
| 2135101077 | Bordet Gengou Agar (Sheep Blood 15%), 20 plates 90 mm, 30 cajas, LIOFILCHEM« | 5/12 dĒas | 1 |
| 2135101078 | Bordet Gengou Agar (Sheep Blood 15%), 100 plates, 6 cajas, LIOFILCHEM« | 5/12 dĒas | 1 |
| 2135101079 | Brain Heart Infusion Agar, 20 plates 90 mm, Medium for cultivation of fastidious aerobic and anaerobic bacteria, LIOFILCHEM« | 5/12 dĒas | 1 |
| 2135101080 | Brain Heart Infusion Agar, 100 plates 90 mm, Medium for cultivation of fastidious aerobic and anaerobic bacteria, LIOFILCHEM« | 5/12 dĒas | 1 |
| 2135101086 | Brilliant Green Agar, 20 plates 90 mm, Selective medium for Salmonella spp. isolation other than S. typhi, LIOFILCHEM« | 5/12 dĒas | 1 |
| 2135101087 | Brilliant Green Agar, 100 plates 90 mm, Selective medium for Salmonella spp. isolation other than S. typhi, LIOFILCHEM« | 5/12 dĒas | 1 |
| 2135101090 | Brucella Blood Agar w Hemin and Vitamin K1, 20 plates 90 mm, Selective medium for Brucella spp. Isolation, LIOFILCHEM« | 5/12 dĒas | 1 |
| 2135101106 | Burkholderia cepacia Selective Agar (BCSA), 20 plates 90 mm, Selective medium for the isolation of Burkholderia cepacia from clinical and non-clinical specimens, LIOFILCHEM« | 5/12 dĒas | 1 |
| 2135101107 | Campylobacter Agar (Sheep blood 10%), 20 plates 90 mm, Selective medium for Campylobacter spp. Isolation, LIOFILCHEM« | 5/12 dĒas | 1 |
| 2135101108 | Campylobacter Agar (Sheep blood 5%), 20 plates 90 mm, Selective medium for Campylobacter spp. Isolation, LIOFILCHEM« | 5/12 dĒas | 1 |
| 2135101109 | Campylobacter Agar (Sheep blood 5%), 100 plates 90 mm, Selective medium for Campylobacter spp. Isolation, LIOFILCHEM« | 5/12 dĒas | 1 |
| 2135101113 | Campylobacter CCDA Agar, 20 plates 90 mm, Selective medium for Campylobacter spp. Isolation, LIOFILCHEM« | 5/12 dĒas | 1 |
| 2135101114 | Campylobacter Karmali AGAR, 20 plates 90 mm, Selective medium for Campylobacter spp. isolation from clinical samples, LIOFILCHEM« | 5/12 dĒas | 1 |
| 2135101115 | Campylobacter Preston Agar, 20 plates 90 mm, Selective medium for Campylobacter spp. detection from clinical specimens, LIOFILCHEM« | 5/12 dĒas | 1 |
| 2135101116 | Campylobacter Skirrow Agar, 20 plates 90 mm, 20 cajas, LIOFILCHEM« | 5/12 dĒas | 1 |
| 2135101119 | Cetrimide Agar, 20 plates 90 mm, Selective Medium for Pseudomonas aeruginosa isolation, LIOFILCHEM« | 5/12 dĒas | 1 |
| 2135101120 | Cetrimide Agar, 100 plates 90 mm, Selective Medium for Pseudomonas aeruginosa isolation, LIOFILCHEM« | 5/12 dĒas | 1 |
| 2135101123 | Chocolate Agar, 20 plates 90 mm, Medium for fastidious microorganisms isolation, LIOFILCHEM« | 5/12 dĒas | 1 |
| 2135101124 | Chocolate Agar, 100 plates 90 mm, Medium for fastidious microorganisms isolation, LIOFILCHEM« | 5/12 dĒas | 1 |
| 2135101128 | Chocolate Agar w/ Bacitracin, Vancomycin, Clindamycin, 20 plates 90 mm, 40 cajas, LIOFILCHEM« | 5/12 dĒas | 1 |
| 2135101129 | Chocolate Agar w/ Cysteine, Sodium Sulfite, Amphotericin B, 20 plates 90 mm, 40 cajas, LIOFILCHEM« | 5/12 dĒas | 1 |
| 2135101130 | Chocolate Agar w/ Streptomycin, 20 plates 90 mm, 40 cajas, LIOFILCHEM« | 5/12 dĒas | 1 |
| 2135101131 | Chocolate Agar w/ Trimethoprim, Clyndamycin, Amphotericin B, 20 plates 90 mm, 40 cajas, LIOFILCHEM« | 5/12 dĒas | 1 |
| 2135101132 | Chocolate Agar w/o VITOX, 20 plates 90 mm, 30 cajas, LIOFILCHEM« | 5/12 dĒas | 1 |
| 2135101133 | Chocolate Bacitracin Agar, 20 plates 90 mm, Selective medium for Haemophilus spp. Isolation, LIOFILCHEM« | 5/12 dĒas | 1 |
| 2135101134 | Chocolate Bacitracin Agar, 100 plates 90 mm, Selective medium for Haemophilus spp. Isolation, LIOFILCHEM« | 5/12 dĒas | 1 |
| 2135101137 | Christensen Urea Agar, 20 plates 90 mm, Medium for enterobacteria urease test, 20 cajas, LIOFILCHEM« | 5/12 dĒas | 1 |
| 2135101138 | Chromatic? MH, 20 plate 90 mm, chromogenic medium for the presumptive identification and susceptibility testing of bacteria directly from clinical and environmental specimens, LIOFILCHEM« | 5/12 dĒas | 1 |
| 2135101140 | CLED Agar, 20 plates 90 mm, Medium for total bacterial count in urine, LIOFILCHEM« | 5/12 dĒas | 1 |
| 2135101141 | CLED Agar, 100 plates 90 mm, Medium for total bacterial count in urine, LIOFILCHEM« | 5/12 dĒas | 1 |
| 2135101145 | CLED Andrade Agar, 20 plates 90 mm, Medium for total bacterial count of urine, 30 cajas, LIOFILCHEM« | 5/12 dĒas | 1 |
| 2135101146 | CLED Andrade Agar, 100 plates 90 mm, Medium for total bacterial count of urine, 6 cajas, LIOFILCHEM« | 5/12 dĒas | 1 |
| 2135101148 | Clostridium Agar (Sheep Blood 5%), 20 plates 90 mm, Selective Medium for Clostridium difficile isolation, LIOFILCHEM« | 5/12 dĒas | 1 |
| 2135101149 | Clostridium Agar (Sheep Blood 5%), 100 plates 90 mm, Selective Medium for Clostridium difficile isolation, 4 cajas, LIOFILCHEM« | 5/12 dĒas | 1 |
| 2135101153 | Columbia Agar (Horse blood 5%), 20 plates 90 mm, Medium for streptococci, staphylococci and pneumococci isolation, LIOFILCHEM« | 5/12 dĒas | 1 |
| 2135101154 | Columbia Agar (Horse blood 5%), 100 plates 90 mm, Medium for streptococci, staphylococci and pneumococci isolation, LIOFILCHEM« | 5/12 dĒas | 1 |
| 2135101155 | Columbia Agar (Sheep blood 5%), 20 plates 90 mm, Medium for fastidious microorganisms isolation, LIOFILCHEM« | 5/12 dĒas | 1 |
| 2135101156 | Columbia Agar (Sheep blood 5%), 100 plates 90 mm, Medium for fastidious microorganisms isolation, LIOFILCHEM« | 5/12 dĒas | 1 |
| 2135101157 | Columbia Agar (Sheep blood 5%) + Vancomycin, 20 plates 90 mm, medium for identification and differentiation of heteroresistant Vancomycin-intermediate S.aureus (h-VISA) and Vancomycin-intermediate S.aureus (VISA) from Vancomycin-susceptible S.aureus (VSSA), 20 cajas, LIOFILCHEM« | 5/12 dĒas | 1 |
| 2135101158 | Columbia CNA Agar (Sheep blood 5%), 20 plates 90 mm, Medium for streptococci, staphylococci and pneumococci isolation, LIOFILCHEM« | 5/12 dĒas | 1 |
| 2135101159 | Columbia CNA Agar (Sheep blood 5%), 100 plates 90 mm, Medium for streptococci, staphylococci and pneumococci isolation, LIOFILCHEM« | 5/12 dĒas | 1 |
| 2135101163 | Columbia CNA Modified Agar (Sheep blood 5%), 20 plates 90 mm, Selective medium for streptococci isolation, LIOFILCHEM« | 5/12 dĒas | 1 |
| 2135101164 | Columbia CNA Modified Agar (Sheep blood 5%), 100 plates 90 mm, Selective medium for streptococci isolation, LIOFILCHEM« | 5/12 dĒas | 1 |
| 2135101168 | Corn Meal Agar, 20 plates 90 mm, Medium for cultivating yeasts, 10 cajas, LIOFILCHEM« | 5/12 dĒas | 1 |
| 2135101169 | Crystal Violet Agar (Sheep blood 5%), 20 plates 90 mm, Selective medium for streptococci isolation, 30 cajas, LIOFILCHEM« | 5/12 dĒas | 1 |
| 2135101170 | Crystal Violet Agar (Sheep blood 5%), 100 plates 90 mm, Selective medium for streptococci isolation, 6 cajas, LIOFILCHEM« | 5/12 dĒas | 1 |
| 2135101171 | Crystal Violet Medium, 20 plates 90 mm, Selective medium for streptococci isolation, 20 cajas, LIOFILCHEM« | 5/12 dĒas | 1 |
| 2135101172 | Czapek Dox Agar, 20 plates 90 mm, Selective medium for saprophytic fungi cultivation, LIOFILCHEM« | 5/12 dĒas | 1 |
| 2135101177 | Dermatophyte (D.T.M.) Agar, 20 plates 90 mm, Selective medium for dermatophyte fungi isolation, LIOFILCHEM« | 5/12 dĒas | 1 |
| 2135101178 | Dermatophyte (D.T.M.) Agar, 100 plates, Selective medium for dermatophyte fungi isolation, LIOFILCHEM« | 5/12 dĒas | 1 |
| 2135101181 | Desoxycholate Agar, 20 plates 90 mm, Selective medium for enterobacteria isolation, LIOFILCHEM« | 5/12 dĒas | 1 |
| 2135101184 | Dichloran Rose Bengal CAF Agar, 20 plates 90 mm, Selective medium for detecting yeasts and moulds in foods, LIOFILCHEM« | 5/12 dĒas | 1 |
| 2135101185 | Dichloran Rose Bengal CAF Agar, 100 plates 90 mm, Selective medium for detecting yeasts and moulds in foods, LIOFILCHEM« | 5/12 dĒas | 1 |
| 2135101187 | Dichloran Glycerol (DG18) Agar, 20 plates 90 mm, Selective medium for the enumeration of yeasts and moulds, LIOFILCHEM« | 5/12 dĒas | 1 |
| 2135101189 | DNA Agar + BLU Toluidina, 20 plates 90 mm, LIOFILCHEM« | 5/12 dĒas | 1 |
| 2135101190 | DNase TEST AGAR, 20 plates 90 mm, 30 cajas, LIOFILCHEM« | 5/12 dĒas | 1 |
| 2135101191 | DNase TEST AGAR, 100 plates 90 mm, 6 cajas, LIOFILCHEM« | 5/12 dĒas | 1 |
| 2135101192 | Drigalski Lactose Agar, 20 plates 90 mm, 20 cajas, LIOFILCHEM« | 5/12 dĒas | 1 |
| 2135101197 | E.M.B. Levine Agar, 20 plates 90 mm, Selective medium for gram-negative enteric bacteria isolation, LIOFILCHEM« | 5/12 dĒas | 1 |
| 2135101198 | E.M.B. Levine Agar, 100 plates 90 mm, Selective medium for gram-negative enteric bacteria isolation, LIOFILCHEM« | 5/12 dĒas | 1 |
| 2135101201 | Enterobacter (Cronobacter) sakazakii isolation Agar, 20 plates 90 mm, Selective medium for Cronobacter sakazakii isolation, LIOFILCHEM« | 5/12 dĒas | 1 |
| 2135101202 | Enterococco Agar (Bile Aesculin Azide Agar), 20 plates 90 mm, Selective medium for group D streptococci isolation, LIOFILCHEM« | 5/12 dĒas | 1 |
| 2135101203 | Enterococco Agar (Bile Aesculin Azide Agar), 100 plates 90 mm, Selective medium for group D streptococci isolation, LIOFILCHEM« | 5/12 dĒas | 1 |
| 2135101204 | Enterococcus Agar + Vancomycin, 20 plates 90 mm, Selective medium for detecting and counting Vancomycin-resistant enterococci, LIOFILCHEM« | 5/12 dĒas | 1 |
| 2135101205 | Enterococcus Screen Agar 4 sectors, 20 plates 90 mm, Four media in one plate for detecting high level Vancomycin and Aminoglycoside resistant enterococci, LIOFILCHEM« | 5/12 dĒas | 1 |
| 2135101206 | Eugon LT 100 Agar, 20 plates 90 mm, Medium for detection and enumeration of mesophilic bacteria in cosmetic products, 30 cajas, LIOFILCHEM« | 5/12 dĒas | 1 |
| 2135101235 | Gardnerella Agar (5% S. Umano), 20 plates 90 mm, LIOFILCHEM« | 5/12 dĒas | 1 |
| 2135101236 | Gardnerella Agar (Sheep blood 5%), 20 plates 90 mm, Selective Medium for Gardnerella vaginalis isolation, LIOFILCHEM« | 5/12 dĒas | 1 |
| 2135101237 | Gardnerella Agar (Sheep blood 5%), 100 plates 90 mm, Selective Medium for Gardnerella vaginalis isolation, LIOFILCHEM« | 5/12 dĒas | 1 |
| 2135101238 | GBS Agar (Granada), 20 plates 90 mm, Medium for the isolation and identification of Streptococcus agalatiae (Group B Streptococci), LIOFILCHEM« | 5/12 dĒas | 1 |
| 2135101239 | Gelatin Peptone Agar, 20 plates 90 mm, LIOFILCHEM« | 5/12 dĒas | 1 |
| 2135101240 | Group A Selective Strep Agar w/ 5% Sheep Blood, 20 plates 90 mm, 40 cajas, LIOFILCHEM« | 5/12 dĒas | 1 |
| 2135101244 | Haemophilus Test Agar, 20 plates 90 mm, Medium for Haemophilus spp. sensitivity testing, LIOFILCHEM« | 5/12 dĒas | 1 |
| 2135101246 | Helicobacter pylori Agar, 20 plates 90 mm, Selective medium for Helicobacter pylori isolation, LIOFILCHEM« | 5/12 dĒas | 1 |
| 2135101247 | Helicobacter pylori Egg Yolk Emulsion Agar, 20 plates 90 mm, Medium for the cultivation of Helicobacter pylori, 20 cajas, LIOFILCHEM« | 5/12 dĒas | 1 |
| 2135101249 | Hektoen Enteric Agar, 20 plates 90 mm, Selective medium for pathogenic enterobacteria isolation, LIOFILCHEM« | 5/12 dĒas | 1 |
| 2135101250 | Hektoen Enteric Agar, 100 plates 90 mm, Selective medium for pathogenic enterobacteria isolation, LIOFILCHEM« | 5/12 dĒas | 1 |
| 2135101253 | Herellea Agar, 20 plates 90 mm, Selective medium for gram negative bacteria isolation, 30 cajas, LIOFILCHEM« | 5/12 dĒas | 1 |
| 2135101254 | Herellea Agar, 100 plates 90 mm, Selective medium for gram negative bacteria isolation, 6 cajas, LIOFILCHEM« | 5/12 dĒas | 1 |
| 2135101255 | Isosensitest Agar, 20 plates 90 mm, Medium for susceptibility test, LIOFILCHEM« | 5/12 dĒas | 1 |
| 2135101256 | Isosensitest Agar, 100 plates 90 mm, Medium for susceptibility test, LIOFILCHEM« | 5/12 dĒas | 1 |
| 2135101257 | I.U.T.M. Medium, 10 tubes, Medium for mycobacteria detection and sensitivity test, LIOFILCHEM« | 5/12 dĒas | 1 |
| 2135101273 | LBS Medium, 20 plates 90 mm, LIOFILCHEM« | 5/12 dĒas | 1 |
| 2135101274 | Legionella BCYE Agar, 20 plates 90 mm, Non-selective medium for Legionella spp. Isolation, LIOFILCHEM« | 5/12 dĒas | 1 |
| 2135101275 | Legionella BCYE Agar, 100 plates 90 mm, Non-selective medium for Legionella spp. Isolation, LIOFILCHEM« | 5/12 dĒas | 1 |
| 2135101276 | Legionella BCYE Agar w/o cysteine, 20 plates 90 mm, Non-selective medium for Legionella spp. Isolation, LIOFILCHEM« | 5/12 dĒas | 1 |
| 2135101277 | Legionella BCYE Agar w/ Vancomycin + Colistin, 20 plates 90 mm, Selective medium for Legionella spp. Isolation, 30 cajas, LIOFILCHEM« | 5/12 dĒas | 1 |
| 2135101278 | Legionella BMPA Agar, 20 plates 90 mm, Selective medium for Legionella spp. Isolation, LIOFILCHEM« | 5/12 dĒas | 1 |
| 2135101279 | Legionella C.Y.G. Agar, 20 plates 90 mm, Selective medium for Legionella spp. Isolation, 10 cajas, LIOFILCHEM« | 5/12 dĒas | 1 |
| 2135101280 | Legionella GVPC Agar, 20 plates 90 mm, Selective medium for Legionella spp. Isolation, LIOFILCHEM« | 5/12 dĒas | 1 |
| 2135101281 | Legionella GVPC Agar, 100 plates 90 mm, Selective medium for Legionella spp. Isolation, LIOFILCHEM« | 5/12 dĒas | 1 |
| 2135101282 | Legionella MWY Agar, 20 plates 90 mm, Selective medium for Legionella spp. Isolation, LIOFILCHEM« | 5/12 dĒas | 1 |
| 2135101283 | Legionella MWY Agar, 100 plates 90 mm, Selective medium for Legionella spp. Isolation, LIOFILCHEM« | 5/12 dĒas | 1 |
| 2135101285 | Listeria Aesculin Agar, 20 plates 90 mm, Selective Medium for Listeria spp. Isolation, LIOFILCHEM« | 5/12 dĒas | 1 |
| 2135101286 | Listeria Aesculin Agar, 100 plates 90 mm, Selective Medium for Listeria spp. Isolation, LIOFILCHEM« | 5/12 dĒas | 1 |
| 2135101291 | Listeria PALCAM Agar, 20 plates 90 mm, Selective medium for Listeria spp. Isolation, LIOFILCHEM« | 5/12 dĒas | 1 |
| 2135101303 | M17 Agar, 20 plates 90 mm, Medium for lactic streptococci enumeration, 10 cajas, LIOFILCHEM« | 5/12 dĒas | 1 |
| 2135101305 | m-CP Agar, 20 plates 90 mm, 20 cajas, LIOFILCHEM« | 5/12 dĒas | 1 |
| 2135101306 | MRS Agar, 20 plates 90 mm, Medium for lactobacilli isolation, LIOFILCHEM« | 5/12 dĒas | 1 |
| 2135101307 | MRS Agar, 100 plates 90 mm, Medium for lactobacilli isolation, LIOFILCHEM« | 5/12 dĒas | 1 |
| 2135101309 | MSRV Agar (Modified Semisolid Rappaport Vassiliadis), 20 plates 90 mm, Selective medium for Salmonella spp. Isolation, LIOFILCHEM« | 5/12 dĒas | 1 |
| 2135101310 | MSRV Agar (Modified Semisolid Rappaport Vassiliadis), 100 plates 90 mm, Selective medium for Salmonella spp. Isolation, LIOFILCHEM« | 5/12 dĒas | 1 |
| 2135101313 | MacConkey Agar, 20 plates 90 mm, Selective medium for Gram-negative bacteria isolation, LIOFILCHEM« | 5/12 dĒas | 1 |
| 2135101314 | MacConkey Agar, 100 plates 90 mm, Selective medium for Gram-negative bacteria isolation, LIOFILCHEM« | 5/12 dĒas | 1 |
| 2135101318 | MacConkey II Agar, 20 plates 90 mm, Selective medium for the detection of enterococci, in the presence of coliforms and non-lactose fermenters from water, sewage, food products, etc, LIOFILCHEM« | 5/12 dĒas | 1 |
| 2135101319 | MacConkey Agar no.2, 20 plates 90 mm, Selective medium for the detection of enterococci, in the presence of coliforms and non-lactose fermenters from water, sewage, food products, etc, 20 cajas, LIOFILCHEM« | 5/12 dĒas | 1 |
| 2135101320 | MacConkey Agar no.2, 100 plates 90 mm, Selective medium for the detection of enterococci, in the presence of coliforms and non-lactose fermenters from water, sewage, food products, etc, 4 cajas, LIOFILCHEM« | 5/12 dĒas | 1 |
| 2135101324 | MacConkey MUG Agar, 20 plates 90 mm, Selective medium for Escherichia coli isolation, 10 cajas, LIOFILCHEM« | 5/12 dĒas | 1 |
| 2135101325 | MacConkey Agar w/o CRYSTAL VIOLET, 20 plates 90 mm, 20 cajas, LIOFILCHEM« | 5/12 dĒas | 1 |
| 2135101326 | MacConkey Agar w/o NaCl, 20 plates 90 mm, LIOFILCHEM« | 5/12 dĒas | 1 |
| 2135101327 | MacConkey Sorbitol Agar, 20 plates 90 mm, Selective medium for Escherichia coli O157 isolation, LIOFILCHEM« | 5/12 dĒas | 1 |
| 2135101329 | MacConkey S-CT Agar E.Coli O157, 20 plates 90 mm, Selective and differential medium for the detection of Escherichia coli serotype O157:H7, LIOFILCHEM« | 5/12 dĒas | 1 |
| 2135101331 | Malt Agar, 20 plates 90 mm, Medium for yeasts and moulds isolation, 20 cajas, LIOFILCHEM« | 5/12 dĒas | 1 |
| 2135101332 | Malt Extract Agar, 20 plates 90 mm, Medium for yeasts and moulds isolation, 50 cajas, LIOFILCHEM« | 5/12 dĒas | 1 |
| 2135101334 | Mannitol Salt Agar, 20 plates 90 mm, Selective medium for pathogenic staphylococci isolation (harmonized European Pharmacopoeia), LIOFILCHEM« | 5/12 dĒas | 1 |
| 2135101335 | Mannitol Salt Agar, 100 plates 90 mm, Selective medium for pathogenic staphylococci isolation (harmonized European Pharmacopoeia), LIOFILCHEM« | 5/12 dĒas | 1 |
| 2135101339 | Marine Salt Agar, 20 plates 90 mm, Medium for cultivating heterotrophic marine bacteria, 30 cajas, LIOFILCHEM« | 5/12 dĒas | 1 |
| 2135101340 | Mannitol Salt Agar modified, 100 plates 90 mm, Selective medium for pathogenic staphylococci isolation (harmonized European Pharmacopoeia), 8 cajas, LIOFILCHEM« | 5/12 dĒas | 1 |
| 2135101341 | Marine Salt Cycloheximide Agar, 20 plates 90 mm, Medium for cultivating heterotrophic marine bacteria with inhibition of bacterivores, 30 cajas, LIOFILCHEM« | 5/12 dĒas | 1 |
| 2135101342 | Martin Lewis Modified, 20 plates 90 mm, 20 cajas, LIOFILCHEM« | 5/12 dĒas | 1 |
| 2135101348 | m-ENDO Agar LES, 20 plates 90 mm, Medium for coliforms isolation and enumeration in water by membrane filtration, LIOFILCHEM« | 5/12 dĒas | 1 |
| 2135101349 | m-ENDO Agar LES, 100 plates 90 mm, Medium for coliforms isolation and enumeration in water by membrane filtration, LIOFILCHEM« | 5/12 dĒas | 1 |
| 2135101350 | m-FAECAL COLIFORM Agar, 20 plates 90 mm, Selective Medium for fecal coliforms isolation and enumeration in water by membrane filtration, LIOFILCHEM« | 5/12 dĒas | 1 |
| 2135101351 | m-FAECAL COLIFORM Agar, 100 plates 90 mm, Selective Medium for fecal coliforms isolation and enumeration in water by membrane filtration, LIOFILCHEM« | 5/12 dĒas | 1 |
| 2135101354 | MIDDLEBROOK 7H11 Agar, 20 plates 90 mm, Medium for growing and isolating mycobacteria, LIOFILCHEM« | 5/12 dĒas | 1 |
| 2135101356 | Milk Plate Count Agar, 20 plates 90 mm, Medium for the isolation and enumeration of microorganisms in milk and dairy products, 40 cajas, LIOFILCHEM« | 5/12 dĒas | 1 |
| 2135101357 | Milk Plate Count Agar, 100 plates, Medium for the isolation and enumeration of microorganisms in milk and dairy products, 8 cajas, LIOFILCHEM« | 5/12 dĒas | 1 |
| 2135101363 | Monsur Agar, 20 plates 90 mm, 20 cajas, LIOFILCHEM« | 5/12 dĒas | 1 |
| 2135101368 | Mueller Hinton Agar + 5% Horse blood lysed, 20 plates 90 mm, 15 cajas, LIOFILCHEM« | 5/12 dĒas | 1 |
| 2135101369 | Mueller Hinton Agar II, 20 plates 90 mm, Medium for susceptibility test (Kirby Bauer method), low concentration of thymine-thymidine with Ca++ and Mg++, LIOFILCHEM« | 5/12 dĒas | 1 |
| 2135101370 | Mueller Hinton Agar II, 100 plates 90 mm, Medium for susceptibility test (Kirby Bauer method), low concentration of thymine-thymidine with Ca++ and Mg++, LIOFILCHEM« | 5/12 dĒas | 1 |
| 2135101378 | Mueller Hinton Agar II + 2% NaCl, 20 plates 90 mm, Medium for antimicrobial susceptibility testing of staphylococci with Oxacillin, LIOFILCHEM« | 5/12 dĒas | 1 |
| 2135101379 | Mueller Hinton Agar II + Cloxacillin, 20 plates 90 mm, Medium for the screening of ESBL producing Enterobacteriaceae, 10 cajas, LIOFILCHEM« | 5/12 dĒas | 1 |
| 2135101382 | Mueller Hinton Agar II (Sheep blood 5%), 20 plates 90 mm, Medium for susceptibility testing to antibiotics of fastidious microorganisms, LIOFILCHEM« | 5/12 dĒas | 1 |
| 2135101383 | Mueller Hinton Agar II (Sheep blood 5%), 100 plates 90 mm, Medium for susceptibility testing to antibiotics of fastidious microorganisms, LIOFILCHEM« | 5/12 dĒas | 1 |
| 2135101385 | Mueller Hinton Fastidious Agar (Horse blood 5% + 20 mg/L ?-NAD), 20 plates 90 mm, Medium for antimicrobial susceptibility testing of Streptococcus spp., Haemophilus spp., and some other fastidious organisms, LIOFILCHEM« | 5/12 dĒas | 1 |
| 2135101387 | Mueller Hinton Agar w VITALEX, 20 plates 90 mm, 20 cajas, LIOFILCHEM« | 5/12 dĒas | 1 |
| 2135101388 | Mueller Hinton Chocolate Agar, 20 plates 90 mm, LIOFILCHEM« | 5/12 dĒas | 1 |
| 2135101394 | Mycoplasma Agar, 20 plates 90 mm, Selective medium for isolating urogenital mycoplasma, LIOFILCHEM« | 5/12 dĒas | 1 |
| 2135101396 | Mycosel Agar, 20 plates 90 mm, Selective medium for pathogenic fungi isolation, LIOFILCHEM« | 5/12 dĒas | 1 |
| 2135101397 | Mycosel Agar, 100 plates 90 mm, Selective medium for pathogenic fungi isolation, LIOFILCHEM« | 5/12 dĒas | 1 |
| 2135101399 | Neomycin blood Agar (Sheep Blood 5%), 20 plates 90 mm, 30 cajas, LIOFILCHEM« | 5/12 dĒas | 1 |
| 2135101400 | Neomycin blood Agar (Sheep Blood 5%), 100 plates 90 mm, 6 cajas, LIOFILCHEM« | 5/12 dĒas | 1 |
| 2135101402 | New York City Agar, 20 plates 90 mm, 20 cajas, LIOFILCHEM« | 5/12 dĒas | 1 |
| 2135101403 | Nutrient Agar ISO 16266, 20 plates 90 mm, Medium for microorganism growth and enumeration, LIOFILCHEM« | 5/12 dĒas | 1 |
| 2135101404 | Nutrient Agar ISO 16266, 100 plates 90 mm, Medium for microorganism growth and enumeration, LIOFILCHEM« | 5/12 dĒas | 1 |
| 2135101405 | Nutrient Agar ISO 21528, 20 plates 90 mm, Medium for microorganism growth and enumeration, LIOFILCHEM« | 5/12 dĒas | 1 |
| 2135101406 | Nutrient Agar ISO 6579, 20 plates 90 mm, Medium for microorganism growth and enumeration, LIOFILCHEM« | 5/12 dĒas | 1 |
| 2135101407 | Nutrient Agar ISTISAN, 20 plates 90 mm, LIOFILCHEM« | 5/12 dĒas | 1 |
| 2135101417 | Nutrient Sucrose Agar, 20 plates 90 mm, 30 cajas, LIOFILCHEM« | 5/12 dĒas | 1 |
| 2135101419 | O.G.Y.E. Agar (Oxytetracycline), 20 plates 90 mm, Selective medium for yeasts and moulds isolation, LIOFILCHEM« | 5/12 dĒas | 1 |
| 2135101420 | O.G.Y.E. Agar (Oxytetracycline), 100 plates 90 mm, Selective medium for yeasts and moulds isolation, LIOFILCHEM« | 5/12 dĒas | 1 |
| 2135101421 | O.G.Y.E. Agar + Gentamicin, 20 plates 90 mm, 20 cajas, LIOFILCHEM« | 5/12 dĒas | 1 |
| 2135101423 | Orange Serum Agar, 20 plates 90 mm, Medium for isolation and count of bacteria and yeasts in citrus fruits and derivates, 10 cajas, LIOFILCHEM« | 5/12 dĒas | 1 |
| 2135101424 | Oxacillin Resistance Staphylococcus Agar, 20 plates 90 mm, LIOFILCHEM« | 5/12 dĒas | 1 |
| 2135101425 | PAR TEST Agar, 20 plates 90 mm, Medium containing spores of Geobacillus stearothermophilus var. calidolactis C953 for residual antibiotic detection in biological liquids, milk and food, LIOFILCHEM« | 5/12 dĒas | 1 |
| 2135101426 | BLANK DISCS, 250 discs, Paper discs, LIOFILCHEM« | 5/12 dĒas | 1 |
| 2135101437 | Plate Count Agar, 20 placas 90 mm, Placas preparadas c/ medio de cultivo PCA para recuento total de bacterias en aguas y alimentaci¾n, s/ normas APHA e ISO 4833, LIOFILCHEM« | 2/9 dĒas | 1 |
| 2135101438 | Plate Count Agar, 100 plates 90 mm, Placas preparadas c/ medio PCA, Medium for bacterial count in water and foodstuffs, LIOFILCHEM« | 5/12 dĒas | 1 |
| 2135101445 | Plate Count Agar + TTC, 20 plates 90 mm, Placas preparadas c/ medio PCA + TTC, 20 cajas, LIOFILCHEM« | 5/12 dĒas | 1 |
| 2135101446 | Potato Dextrose Agar, 20 plates 90 mm, Medium for yeasts and moulds enumeration, LIOFILCHEM« | 5/12 dĒas | 1 |
| 2135101447 | Potato Dextrose Agar, 100 plates 90 mm, Medium for yeasts and moulds enumeration, LIOFILCHEM« | 5/12 dĒas | 1 |
| 2135101448 | Pseudomonas CN Agar, 20 plates 90 mm, Selective medium for Pseudomonas spp. Isolation, LIOFILCHEM« | 5/12 dĒas | 1 |
| 2135101449 | Pseudomonas Selective Agar (CFC) (Cetrimide, Fucidin, Cephaloridine), 20 plates 90 mm, Selective medium for Pseudomonas spp. Isolation, LIOFILCHEM« | 5/12 dĒas | 1 |
| 2135101450 | Pseudomonas Isolation Agar, 20 plates 90 mm, Selective medium for Pseudomonas spp. Isolation, 20 cajas, LIOFILCHEM« | 5/12 dĒas | 1 |
| 2135101451 | Pseudomonas Isolation Agar, 100 plates 90 mm, Selective medium for Pseudomonas spp. Isolation, 4 cajas, LIOFILCHEM« | 5/12 dĒas | 1 |
| 2135101452 | Purple Glucose Agar, 20 plates 90 mm, 30 cajas, LIOFILCHEM« | 5/12 dĒas | 1 |
| 2135101454 | Purple Lactose Agar, 20 plates 90 mm, 4 cajas, LIOFILCHEM« | 5/12 dĒas | 1 |
| 2135101456 | R2A Agar, 20 plates 90 mm, Medium for heterotrophic microorganisms count in drinking water, LIOFILCHEM« | 5/12 dĒas | 1 |
| 2135101463 | Rogosa Agar, 20 plates 90 mm, Selective medium for lactobacilli isolation and enumeration, LIOFILCHEM« | 5/12 dĒas | 1 |
| 2135101464 | Rogosa Agar, 100 plates 90 mm, Selective medium for lactobacilli isolation and enumeration, LIOFILCHEM« | 5/12 dĒas | 1 |
| 2135101465 | Rose Bengal CAF Agar, 20 plates 90 mm, Selective medium for yeasts and moulds isolation and enumeration, LIOFILCHEM« | 5/12 dĒas | 1 |
| 2135101466 | Rose Bengal CAF Agar, 100 plates 90 mm, Selective medium for yeasts and moulds isolation and enumeration, LIOFILCHEM« | 5/12 dĒas | 1 |
| 2135101468 | RPMI Agar (2% glucose + MOPS), 20 plates 90 mm, Medium for antifungal susceptibility testing, LIOFILCHEM« | 5/12 dĒas | 1 |
| 2135101472 | SPS Agar, 20 plates 90 mm, Medium for Clostridium perfringens isolation and enumeration, LIOFILCHEM« | 5/12 dĒas | 1 |
| 2135101473 | SPS Agar, 100 plates 90 mm, Medium for Clostridium perfringens isolation and enumeration, LIOFILCHEM« | 5/12 dĒas | 1 |
| 2135101477 | S.S. Agar, 20 plates 90 mm, Selective medium for Salmonella and Shigella isolation, LIOFILCHEM« | 5/12 dĒas | 1 |
| 2135101478 | S.S. Agar, 100 plates 90 mm, Selective medium for Salmonella and Shigella isolation, LIOFILCHEM« | 5/12 dĒas | 1 |
| 2135101481 | Sabouraud Dextrose Agar, 20 plates 90 mm, Medium for yeasts and moulds isolation, LIOFILCHEM« | 5/12 dĒas | 1 |
| 2135101482 | Sabouraud Dextrose Agar, 20 plates 90 mm Irradiated, Medium for yeasts and moulds isolation, LIOFILCHEM« | 5/12 dĒas | 1 |
| 2135101483 | Sabouraud Dextrose Agar (Irradiated) 30 mL, 20 plates 90 mm, Medium for yeasts and moulds isolation, LIOFILCHEM« | 5/12 dĒas | 1 |
| 2135101484 | Sabouraud Dextrose Agar, 100 plates 90 mm, Medium for yeasts and moulds isolation, LIOFILCHEM« | 5/12 dĒas | 1 |
| 2135101489 | Sabouraud Dextrose Agar + Lactamator 500 IU + Neutralizing (Irradiated), 20 plates 90 mm, Medium for yeasts and moulds isolation with inactivation of ?-lactam antibiotics and disinfectants, 40 cajas, LIOFILCHEM« | 5/12 dĒas | 1 |
| 2135101490 | Sabouraud Dextrose Agar + 0.1% Penase + Neutralizing (Irradiated), 20 plates 90 mm, Medium for yeasts and moulds isolation with inactivation of disinfectants and penicillins, 40 cajas, LIOFILCHEM« | 5/12 dĒas | 1 |
| 2135101491 | Sabouraud CAF Agar, 20 plates 90 mm, Selective medium for pathogenic fungi isolation, LIOFILCHEM« | 5/12 dĒas | 1 |
| 2135101492 | Sabouraud CAF Agar, 100 plates 90 mm, Selective medium for pathogenic fungi isolation, LIOFILCHEM« | 5/12 dĒas | 1 |
| 2135101496 | Sabouraud CAF Agar + Gentamicin, 20 plates 90 mm, Selective medium for pathogenic fungi isolation, LIOFILCHEM« | 5/12 dĒas | 1 |
| 2135101497 | Sabouraud CAF Agar + Gentamicin, 100 plates 90 mm, Selective medium for pathogenic fungi isolation, LIOFILCHEM« | 5/12 dĒas | 1 |
| 2135101498 | Sabouraud CAF Agar + Gentamicin irradiated, 20 plates 90 mm, Selective medium for pathogenic fungi isolation, 20 cajas, LIOFILCHEM« | 5/12 dĒas | 1 |
| 2135101499 | Sabouraud CAF Agar + Neutralizing, 20 plates 90 mm, Selective medium for pathogenic fungi isolation, 40 cajas, LIOFILCHEM« | 5/12 dĒas | 1 |
| 2135101500 | Sabouraud CAF Agar + Neutralizing, 100 plates 90 mm, Selective medium for pathogenic fungi isolation, 8 cajas, LIOFILCHEM« | 5/12 dĒas | 1 |
| 2135101501 | Sabouraud CAF Agar + TTC, 20 plates 90 mm, Selective medium for pathogenic fungi isolation, 20 cajas, LIOFILCHEM« | 5/12 dĒas | 1 |
| 2135101502 | Sabouraud CAF Agar + TTC, 100 plates 90 mm, Selective medium for pathogenic fungi isolation, 4 cajas, LIOFILCHEM« | 5/12 dĒas | 1 |
| 2135101503 | Sabouraud CAF Agar + Penase + Cephalosporinase + Neutralizing (Irradiated), 20 plates 90 mm, Medium for yeasts and moulds isolation with inactivation of disinfectants and penicillins, 40 cajas, LIOFILCHEM« | 5/12 dĒas | 1 |
| 2135101504 | Sabouraud CAF Agar 400 mg, 20 plates 90 mm, 20 cajas, LIOFILCHEM« | 5/12 dĒas | 1 |
| 2135101505 | Sabouraud CAF Agar 50 mg, 20 plates 90 mm, LIOFILCHEM« | 5/12 dĒas | 1 |
| 2135101506 | Sabouraud CAF Agar Irradiated, 20 plates 90 mm, 20 cajas, LIOFILCHEM« | 5/12 dĒas | 1 |
| 2135101507 | Sabouraud Agar + Cycloheximide, 20 plates 90 mm, Selective medium for pathogenic fungi isolation, 20 cajas, LIOFILCHEM« | 5/12 dĒas | 1 |
| 2135101508 | Sabouraud Agar + Gentamicin, 20 plates 90 mm, Selective medium for pathogenic fungi isolation, LIOFILCHEM« | 5/12 dĒas | 1 |
| 2135101509 | Sabouraud Agar + Gentamicin, 100 plates 90 mm, Selective medium for pathogenic fungi isolation, LIOFILCHEM« | 5/12 dĒas | 1 |
| 2135101510 | Sabouraud Agar + Neutralizing, Irradiated, 20 plates 90 mm, Selective medium for pathogenic fungi isolation, 20 cajas, LIOFILCHEM« | 5/12 dĒas | 1 |
| 2135101511 | Sabouraud Agar Modified, 20 plates 90 mm, Selective medium for pathogenic fungi isolation, LIOFILCHEM« | 5/12 dĒas | 1 |
| 2135101512 | Sabouraud Agar Modified, 100 plates 90 mm, Selective medium for pathogenic fungi isolation, LIOFILCHEM« | 5/12 dĒas | 1 |
| 2135101516 | Salmonella Test Agar, 20 plates 90 mm, 30 cajas, LIOFILCHEM« | 5/12 dĒas | 1 |
| 2135101517 | Salmonella Test Agar, 100 plates 90 mm, 6 cajas, LIOFILCHEM« | 5/12 dĒas | 1 |
| 2135101518 | Scedosporium Selective Agar, 20 plates 90 mm, Selective medium for the detection of Scedosporium spp. from clinical specimens., 20 cajas, LIOFILCHEM« | 5/12 dĒas | 1 |
| 2135101520 | Schaedler CNA Agar (Sheep blood 5%), 20 plates 90 mm, Medium for cultivating and isolating fastidious organisms, LIOFILCHEM« | 5/12 dĒas | 1 |
| 2135101521 | Schaedler K Agar (Sheep blood 5%), 20 plates 90 mm, Medium for antimicrobial susceptibility testing of anaerobic bacteria, LIOFILCHEM« | 5/12 dĒas | 1 |
| 2135101522 | Schaedler K Agar (Sheep blood 5%), 100 plates 90 mm, Medium for antimicrobial susceptibility testing of anaerobic bacteria, LIOFILCHEM« | 5/12 dĒas | 1 |
| 2135101523 | Schaedler KKV Agar (Sheep blood 5%), 20 plates 90 mm, Selective medium for anaerobic gram-negative bacteria isolation, LIOFILCHEM« | 5/12 dĒas | 1 |
| 2135101524 | Schaedler KKV Agar (Sheep blood 5%), 100 plates 90 mm, Selective medium for anaerobic gram-negative bacteria isolation, LIOFILCHEM« | 5/12 dĒas | 1 |
| 2135101525 | Schaedler KVN Agar (Sheep Blood 5%), 20 plates 90 mm, Selective medium for anaerobic gram-negative bacteria isolation, 30 cajas, LIOFILCHEM« | 5/12 dĒas | 1 |
| 2135101526 | Serum Tellurite Agar, 20 plates 90 mm, 10 cajas, LIOFILCHEM« | 5/12 dĒas | 1 |
| 2135101527 | Sierra Lypolitic Agar, 20 plates 90 mm, 20 cajas, LIOFILCHEM« | 5/12 dĒas | 1 |
| 2135101540 | Slanetz Bartley Agar, 20 plates 90 mm, Selective medium for fecal streptococci enumeration and isolation, LIOFILCHEM« | 5/12 dĒas | 1 |
| 2135101541 | Slanetz Bartley Agar, 100 plates 90 mm, Selective medium for fecal streptococci enumeration and isolation, LIOFILCHEM« | 5/12 dĒas | 1 |
| 2135101542 | Streptococcal KF+TTC Agar, 20 plates 90 mm, Selective medium for fecal streptococci isolation and enumeration, LIOFILCHEM« | 5/12 dĒas | 1 |
| 2135101543 | Streptococcal KF+TTC Agar, 100 plates 90 mm, Selective medium for fecal streptococci isolation and enumeration, LIOFILCHEM« | 5/12 dĒas | 1 |
| 2135101549 | Sugar Free Agar, 20 plates 90 mm, LIOFILCHEM« | 5/12 dĒas | 1 |
| 2135101550 | TCBS Agar, 20 plates 90 mm, Selective medium for Vibrio spp. Isolation, LIOFILCHEM« | 5/12 dĒas | 1 |
| 2135101551 | TCBS Agar, 100 plates 90 mm, Selective medium for Vibrio spp. Isolation, LIOFILCHEM« | 5/12 dĒas | 1 |
| 2135101552 | T.S.A. + Actidione, 20 plates 90 mm, 20 cajas, LIOFILCHEM« | 5/12 dĒas | 1 |
| 2135101555 | Tergitol TTC Agar (ISO 9308-1), 20 plates 90 mm, Selective medium for coliforms enumeration and identification, 30 cajas, LIOFILCHEM« | 5/12 dĒas | 1 |
| 2135101556 | Tergitol TTC Agar (ISO 9308-1), 100 plates 90 mm, Selective medium for coliforms enumeration and identification, 6 cajas, LIOFILCHEM« | 5/12 dĒas | 1 |
| 2135101557 | Tergitol 7 Agar, 20 plates 90 mm, Selective medium for detecting E. coli and coliforms, 10 cajas, LIOFILCHEM« | 5/12 dĒas | 1 |
| 2135101559 | Thayer-MartinAgar, 20 plates 90 mm, Selective medium for pathogenic neisseriae isolation, LIOFILCHEM« | 5/12 dĒas | 1 |
| 2135101560 | Thayer-MartinAgar, 100 plates 90 mm, Selective medium for pathogenic neisseriae isolation, LIOFILCHEM« | 5/12 dĒas | 1 |
| 2135101561 | Tinsdale Agar, 20 plates 90 mm, 20 cajas, LIOFILCHEM« | 5/12 dĒas | 1 |
| 2135101562 | Tinsdale Agar, 100 plates 90 mm, 4 cajas, LIOFILCHEM« | 5/12 dĒas | 1 |
| 2135101569 | Triple Sugar Iron Agar, 20 plates 90 mm, 20 cajas, LIOFILCHEM« | 5/12 dĒas | 1 |
| 2135101571 | TSA Tryptic Soy Agar, 20 plates 90 mm, Medium for non-fastidious bacteria growth, LIOFILCHEM« | 5/12 dĒas | 1 |
| 2135101572 | TSA Tryptic Soy Agar, 100 plates 90 mm, Medium for non-fastidious bacteria growth, LIOFILCHEM« | 5/12 dĒas | 1 |
| 2135101574 | TSA Tryptic Soy Agar, 20 plates 90 mm Irradiated, Medium for non-fastidious bacteria growth, LIOFILCHEM« | 5/12 dĒas | 1 |
| 2135101575 | TSA Tryptic Soy Agar, 20 plates 18 mL Irrad., Medium for non-fastidious bacteria growth, 30 cajas, LIOFILCHEM« | 5/12 dĒas | 1 |
| 2135101576 | TSA Tryptic Soy Agar, 20 plates 30 mL Irrad., Medium for non-fastidious bacteria growth, LIOFILCHEM« | 5/12 dĒas | 1 |
| 2135101577 | TSA Tryptic Soy Agar, 20 plates 30 mL Irrad., Medium for non-fastidious bacteria growth, 30 cajas, LIOFILCHEM« | 5/12 dĒas | 1 |
| 2135101582 | TSA Tryptic Soy Agar (Horse Blood 5%), 20 plates 90 mm, LIOFILCHEM« | 5/12 dĒas | 1 |
| 2135101583 | TSA Tryptic Soy Agar (Horse Blood 5%), 100 plates 90 mm, LIOFILCHEM« | 5/12 dĒas | 1 |
| 2135101584 | TSA Tryptic Soy Agar (Sheep blood 5%), 20 plates 90 mm, Medium for fastidious bacteria isolation, LIOFILCHEM« | 5/12 dĒas | 1 |
| 2135101585 | TSA Tryptic Soy Agar (Sheep blood 5%), 100 plates 90 mm, Medium for fastidious bacteria isolation, LIOFILCHEM« | 5/12 dĒas | 1 |
| 2135101586 | TSA Tryptic Soy Agar + Lactamator 500 IU + Neutralizing (Irradiated), 20 plates 90 mm, 30 cajas, LIOFILCHEM« | 5/12 dĒas | 1 |
| 2135101587 | TSA Tryptic Soy Agar + Lactamator 500 IU (Irradiated), 20 plates 90 mm, 30 cajas, LIOFILCHEM« | 5/12 dĒas | 1 |
| 2135101588 | TSA Tryptic Soy Agar + Lactamator 500 IU (Irradiated) 30 mL, 20 plates 90 mm, LIOFILCHEM« | 5/12 dĒas | 1 |
| 2135101589 | TSA Tryptic Soy Agar + Lactamator 1000 IU (Irradiated), 20 plates 90 mm, LIOFILCHEM« | 5/12 dĒas | 1 |
| 2135101590 | TSA Tryptic Soy Agar + Lactamator 1000 IU + Neutralizing (Irradiated), 20 plates 90 mm, Irradiated medium for non-fastidious bacteria growth with inactivation of ?-lactam antibiotics and disinfectants, 30 cajas, LIOFILCHEM« | 5/12 dĒas | 1 |
| 2135101591 | TSA Tryptic Soy Agar + Lactamator 1000 IU + Neutralizing (Irradiated), 20 plates 30 mL, Irradiated medium for non-fastidious bacteria growth with inactivation of ?-lactam antibiotics and disinfectants, LIOFILCHEM« | 5/12 dĒas | 1 |
| 2135101592 | TSA Tryptic Soy Agar + Lactamator 1000 IU + Neutralizing (Irradiated) 30 mL, 20 plates 90 mm, 20 cajas, LIOFILCHEM« | 5/12 dĒas | 1 |
| 2135101593 | TSA Tryptic Soy Agar + Neutralizing, 20 plates 90 mm, Irradiated medium for non-fastidious bacteria growth with inactivation of disinfectants, LIOFILCHEM« | 5/12 dĒas | 1 |
| 2135101594 | TSA Tryptic Soy Agar + Neutralizing, 100 plates 90 mm, Irradiated medium for non-fastidious bacteria growth with inactivation of disinfectants, LIOFILCHEM« | 5/12 dĒas | 1 |
| 2135101595 | TSA Tryptic Soy Agar + Neutralizing (Irradiated), 20 plates 90 mm, Irradiated medium for non-fastidious bacteria growth with inactivation of disinfectants, LIOFILCHEM« | 5/12 dĒas | 1 |
| 2135101596 | TSA Tryptic Soy Agar + Neutralizing (Irradiated), 20 plates 30 mL, Irradiated medium for non-fastidious bacteria growth with inactivation of disinfectants, LIOFILCHEM« | 5/12 dĒas | 1 |
| 2135101598 | TSA Tryptic Soy Agar + 0.1% Penase + Neutralizing, 20 plates 90 mm, Medium for bacterial count with inactivation of antibiotics and disinfectants, 30 cajas, LIOFILCHEM« | 5/12 dĒas | 1 |
| 2135101599 | TSA Tryptic Soy Agar + 0.1% Penase + Neutralizing (Irradiated), 20 plates 90 mm, Medium for bacterial count with inactivation of antibiotics and disinfectants, 30 cajas, LIOFILCHEM« | 5/12 dĒas | 1 |
| 2135101600 | TSA Tryptic Soy Agar + 0.1% Penase + Neutralizing (Irradiated), 20 plates 30 mL, Medium for bacterial count with inactivation of antibiotics and disinfectants, 20 cajas, LIOFILCHEM« | 5/12 dĒas | 1 |
| 2135101601 | TSA Tryptic Soy Agar + 0.6% Yeast Extract, 20 plates 90 mm, LIOFILCHEM« | 5/12 dĒas | 1 |
| 2135101602 | TSA Tryptic Soy Agar + 1% Penase + Neutralizing, 20 plates 90 mm, Medium for bacterial count with inactivation of antibiotics and disinfectants, 20 cajas, LIOFILCHEM« | 5/12 dĒas | 1 |
| 2135101603 | TSA Tryptic Soy Agar + 1% Penase + Neutralizing, 100 plates 90 mm, Medium for bacterial count with inactivation of antibiotics and disinfectants, 4 cajas, LIOFILCHEM« | 5/12 dĒas | 1 |
| 2135101604 | TSA Tryptic Soy Agar + 5% Penase + Neutralizing, 20 plates 90 mm, Medium for bacterial count with inactivation of antibiotics and disinfectants, 20 cajas, LIOFILCHEM« | 5/12 dĒas | 1 |
| 2135101605 | TSA Tryptic Soy Agar + NaCl 3%, 20 plates 90 mm, 20 cajas, LIOFILCHEM« | 5/12 dĒas | 1 |
| 2135101606 | TSA Tryptic Soy Agar + Neutralizing + Penase + Cephalosporinase (Irradiated), 20 plates 90 mm, Medium for microbial detection with inactivation of ?-lactam antibiotics and disinfectants, 30 cajas, LIOFILCHEM« | 5/12 dĒas | 1 |
| 2135101607 | TSA Tryptic Soy Agar + TTC + Cysteine, 20 plates 90 mm, 20 cajas, LIOFILCHEM« | 5/12 dĒas | 1 |
| 2135101608 | TSA Tryptic Soy Agar LT 100, 20 plates 90 mm, 20 cajas, LIOFILCHEM« | 5/12 dĒas | 1 |
| 2135101631 | Tryptose Agar, 20 plates 90 mm, 20 cajas, LIOFILCHEM« | 5/12 dĒas | 1 |
| 2135101632 | Tryptose Agar, 100 plates 90 mm, 4 cajas, LIOFILCHEM« | 5/12 dĒas | 1 |
| 2135101633 | Tryptone Soy Yeast Extract Agar, 20 plates 90 mm, Medium for confirmation of Listeria monocytogenes from food, LIOFILCHEM« | 5/12 dĒas | 1 |
| 2135101645 | T.S.A. + Beta Lattamase II, 20 plates 90 mm, 20 cajas, LIOFILCHEM« | 5/12 dĒas | 1 |
| 2135101646 | T.S.A. + Beta Lattamase II + LEC + POL80 + GLY + ST, Irradiated, 20 plates 90 mm, LIOFILCHEM« | 5/12 dĒas | 1 |
| 2135101647 | Vancomycin Screen Agar, 20 plates 90 mm, 10 cajas, LIOFILCHEM« | 5/12 dĒas | 1 |
| 2135101648 | Violet Red Bile Glucose Agar, 20 plates 90 mm, Selective Medium for enterobacteria isolation and count, LIOFILCHEM« | 5/12 dĒas | 1 |
| 2135101651 | Violet Red Bile Lactose Agar, 20 plates 90 mm, Selective medium for coliforms isolation and enumeration, LIOFILCHEM« | 5/12 dĒas | 1 |
| 2135101652 | Violet Red Bile Lactose Agar, 100 plates 90 mm, Selective medium for coliforms isolation and enumeration, LIOFILCHEM« | 5/12 dĒas | 1 |
| 2135101655 | Violet Red Bile Lactose Agar + MUG, 20 plates 90 mm, Selective medium for isolation and enumeration of coliforms and E. coli, 20 cajas, LIOFILCHEM« | 5/12 dĒas | 1 |
| 2135101659 | Vogel Johnson Agar, 20 plates 90 mm, Selective Medium for Staphylococcus aureus isolation, 20 cajas, LIOFILCHEM« | 5/12 dĒas | 1 |
| 2135101660 | Vogel Johnson Agar, 100 plates 90 mm, Selective Medium for Staphylococcus aureus isolation, 4 cajas, LIOFILCHEM« | 5/12 dĒas | 1 |
| 2135101661 | Wilkins Chalgren Agar, 20 plates 90 mm, 20 cajas, LIOFILCHEM« | 5/12 dĒas | 1 |
| 2135101662 | Wilkins Chalgren Agar + 5% Sheep Blood, 20 plates 90 mm, LIOFILCHEM« | 5/12 dĒas | 1 |
| 2135101663 | Wurtz Lactose Agar, 20 plates 90 mm, Medium for enterobacteria isolation, LIOFILCHEM« | 5/12 dĒas | 1 |
| 2135101664 | Wurtz Lactose Agar, 100 plates 90 mm, Medium for enterobacteria isolation, LIOFILCHEM« | 5/12 dĒas | 1 |
| 2135101666 | XLD Agar, 20 plates 90 mm, Differential and selective medium for pathogenic enterobacteria isolation, LIOFILCHEM« | 5/12 dĒas | 1 |
| 2135101667 | XLD Agar, 100 plates, Differential and selective medium for pathogenic enterobacteria isolation, LIOFILCHEM« | 5/12 dĒas | 1 |
| 2135101668 | XLD Agar Pharmacopoeia formulation, 20 plates 90 mm, Differential and selective medium for pathogenic enterobacteria isolation, LIOFILCHEM« | 5/12 dĒas | 1 |
| 2135101669 | XLT4 Agar, 20 plates 90 mm, Selective Medium for Salmonella spp. Isolation, LIOFILCHEM« | 5/12 dĒas | 1 |
| 2135101670 | XLT4 Agar, 100 plates, Selective Medium for Salmonella spp. Isolation, LIOFILCHEM« | 5/12 dĒas | 1 |
| 2135101676 | Yeast Glucose Chloramphenicol Agar, 20 plates 90 mm, Selective medium for yeasts and moulds isolation and enumeration, LIOFILCHEM« | 5/12 dĒas | 1 |
| 2135101677 | Yeast Mold Agar, 20 plates 90 mm, LIOFILCHEM« | 5/12 dĒas | 1 |
| 2135101680 | Yersinia Selective Agar, 20 plates 90 mm, Selective medium for Yersinia enterocolitica isolation, LIOFILCHEM« | 5/12 dĒas | 1 |
| 2135101681 | Yersinia Selective Agar, 100 plates, Selective medium for Yersinia enterocolitica isolation, LIOFILCHEM« | 5/12 dĒas | 1 |
| 2135101682 | Yoshinaga Agarr, 20 plates 90 mm, 20 cajas, LIOFILCHEM« | 5/12 dĒas | 1 |
| 2135101683 | YSG Agar, 20 plates 90 mm, Medium for detecting Alicyclobacillus in fruit juices and other beverages, 40 cajas, LIOFILCHEM« | 5/12 dĒas | 1 |
| 2135101684 | YSG Agar, 100 plates 90 mm, Medium for detecting Alicyclobacillus in fruit juices and other beverages, 8 cajas, LIOFILCHEM« | 5/12 dĒas | 1 |
| Código | Descripción | Disponibilidad | Precio 1x (€) |
Cantidad | Añadir | Precio 1x caja (€) |
Cantidad caja |
Añadir |
|---|---|---|---|---|---|---|---|---|
| 2135101246 | Helicobacter pylori Agar, 20 plates 90 mm, Selective medium for Helicobacter pylori isolation, LIOFILCHEM® | 5/12 días | 90,57 | 1 | 28,27 | 5 |